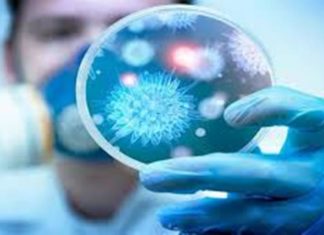
وزارة الصحة تعلن عن دواء فعّال في علاج ”كورونا” ومتوفر في تونس

تجاوز 1500 شخص..أسباب اِرتفاع العزل الصحّي في تونس في ظرف يومين
المنبر التونسي(كورونا) - تحدث شكري حمودة مدير عام رعاية الصحّة الأساسيّة بوزارة الصحة، خلال مؤتمر صحفي عن سبب كثرة أخبار العزل الصحّي في البلاد.
وقال...
وزارة الصحة تعلن عن دواء فعّال في علاج ”كورونا” ومتوفر في تونس
المنبر التونسي(كورونا) - قال شكري حمودة مدير عام رعاية الصحة الأساسية بوزارة الصحة، خلال مؤتمر صحفي اليوم الأربعاء 4 مارس 2020 ، إن أبحاثا...
وزارة الصحة تحذّر : فيروس كورونا ينتقل عبر لمس ” الفلوس”
المنبر التونسي(كورونا) - قال الدكتور شكري حمودة مدير عام إدارة الرعاية الصحيّة الأساسيّة بوزارة الصحّة ، بأن فيروس “كورونا” علميا ينتقل عبر لمس النقود...
وزير الصحة: حوالي 900 شخص خضعوا للحجر الصحي في تونس
المنبر التونسي(وزير الصحة) - كشف اليوم الإربعاء وزير الصحة عبد اللطيف المكي خلال ندوة صحفية أن حولي 900 شخص في تونس خضعوا للحجر الصحي...
فيروس كورونا يمكن له أن يتنقل عبر لمس الأموال؟
المنبر التونسي (كورونا) - قال صباح اليوم الإربعاء الدكتور شكري حمودة مدير عام إدارة الرعاية الصحيّة الأساسيّة بوزارة الصحّة ، بأن فيروس كورونا علميا...
القيروان : من بينهم رضيع..وضع 7 أشخاص في الحجر الصحي
المنبر التونسي(القيروان) - قال المدير الجهوي للصحة بولاية القيروان، حمدي الحذري، أنه تم وضع 7 أشخاص (5 ذكور و2 إناث) من ولاية القيروان، بينهم...
ﺑﻌﺪ ﺗﺴﺠﻴﻞ ﺍﻭﻝ ﺍﺻﺎﺑﺔ ﺑﺎﻟﻜﻮﺭﻭﻧﺎ : ﺗﻮﻧﺲ ﺗﻤﺮ ﻟﻠﺪﺭﺟﺔ ﺍﻟﺜﺎﻧﻴﺔ ﻭﻫﺬﺍ ﻣﺎ ﺗﻨﺺ ﻋﻠﻴﻪ
المنبر التونسي (كورونا فيروس)- ﺑﻌﺪ ﺗﺴﺠﻴﻞ ﺍﻭﻝ ﺍﺻﺎﺑﺔ ﺑﻔﻴﺮﻭﺱ ﻛﻮﺭﻭﻧﺎ ﻓﻲ ﺗﻮﻧﺲ ﻗﺎﻝ ﺍﻟﻤﺪﻳﺮ ﺍﻟﻌﺎﻡ ﻟﻠﺮﻋﺎﻳﺔ ﺍﻟﺼﺤﻴﺔ ﺍﻷﺳﺎﺳﻴﺔ ﺷﻜﺮﻱ ﺣﻤﻮﺩﺓ، ﺍﻟﻴﻮﻡ ﺍﻟﺜﻼﺛﺎﺀ، ﺍﻧﻪ ﺗﻢ...
صفاقس: 11 مواطنا عادوا من إيطاليا في الحجر الصحي
المنبر التونسي(صفاقس) - أكد المدير الجهوي للصحة بصفاقس الدكتور علي العيادي أن المنظومة الاستشفائية الجهوية تؤمن المتابعة والحجر الصحيين لأحد عشر (11) مواطنا ممن...
توقّيا من الكورونا: وزارة الصحة تدعو التونسيين إلى الابتعاد عن الشّيشة
المنبر التونسي(توقيا من كورونا) - دعا المدير العام لإدارة الرعاية الأساسية بوزارة الصحة شكري حمودة في تصريح لإذاعة ifm اليوم الثلاثاء 3 مارس، المواطنين...
نقل المصاب بـ’كورونا’ إلى مستشفى فرحات حشاد… واحتجاج الإطار الطبي على ذلك “التفاصيل “
المنبر التونسي (كورونا فيروس)- أكد المدير الجهوي للصحة بسوسة سامي الرقيق أن المواطن القادم من إيطاليا والمصاب بفيروس ''كورونا'' وصل إلى المستشفى الجامعي فرحات حشاد بعد...